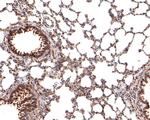
TMEM43 Antibody in Immunohistochemistry (Paraffin) (IHC (P))

Search
Invitrogen
TMEM43 Recombinant Rabbit Monoclonal Antibody (JE65-15)
{{$productOrderCtrl.translations['antibody.pdp.commerceCard.promotion.promotions']}}
{{$productOrderCtrl.translations['antibody.pdp.commerceCard.promotion.viewpromo']}}
{{$productOrderCtrl.translations['antibody.pdp.commerceCard.promotion.promocode']}}: {{promo.promoCode}} {{promo.promoTitle}} {{promo.promoDescription}}. {{$productOrderCtrl.translations['antibody.pdp.commerceCard.promotion.learnmore']}}
图: 1 / 5
TMEM43 Antibody (MA5-44725) in IHC (P)

Please note: We are reviewing Western blot images included in the antibody testing data in our catalog, including those provided by third parties. Unless expressly labeled or annotated as “raw-unedited”, Western blot images included in the antibody testing data in our catalog may have been edited, optimized or otherwise adjusted for presentation.
产品信息
MA5-44725
种属反应
宿主/亚型
Expression System
分类
类型
克隆号
抗原
偶联物
形式
浓度
规格
纯化类型
保存液
内含物
保存条件
运输条件
RRID
靶标信息
This gene belongs to the TMEM43 family. Defects in this gene are the cause of familial arrhythmogenic right ventricular dysplasia type 5 (ARVD5), also known as arrhythmogenic right ventricular cardiomyopathy type 5 (ARVC5). Arrhythmogenic right ventricular dysplasia is an inherited disorder, often involving both ventricles, and is characterized by ventricular tachycardia, heart failure, sudden cardiac death, and fibrofatty replacement of cardiomyocytes. This gene contains a response element for PPAR gamma (an adipogenic transcription factor), which may explain the fibrofatty replacement of the myocardium, a characteristic pathological finding in ARVC.
仅用于科研。不用于诊断过程。未经明确授权不得转售。
篇参考文献 (0)
生物信息学
蛋白别名: Protein LUMA; Transmembrane protein 43
基因别名: 1200015A22Rik; LUMA; TMEM43; UNQ2564/PRO6244
UniProt ID: (Mouse) Q9DBS1, (Rat) Q5XIP9
Entrez Gene ID: (Mouse) 74122, (Rat) 362401




